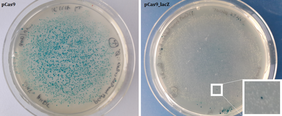

Als das Schul- und Öffentlichkeitslabor Science Bridge e.V. vor etwa zwei Jahren das erste einfache Experiment für Schulen und die allgemeine Öffentlichkeit zur „Genschere“ CRISPR-Cas entwickelte, zeigte die amerikanische Firma miniPCR (Amplyus, Cambridge, MA) Interesse, gemeinsam einen Experimentierbaukasten zu entwickeln. Damit könnte dieses vielseitig anwendbare Werkzeug zur „Genomeditierung“ (Nobelpreis 2020) weltweit auch für Laien „begreifbar“ gemacht werden. Nach etwa einem Jahr intensiver Zusammenarbeit kam jetzt, am 25.5.2021, das CRISPR-Kit „Knockout!“ auf den Markt.
Bei dem Experiment geht es darum, die Funktion der viel diskutierten „Genschere“ CRISPR-Cas sichtbar zu machen:
Ein Stamm des Darmbakteriums E. coli lässt sich auf einfache Art blau anfärben, weil er ein bestimmtes Gen für das Enzym ß-Galaktosidase enthält. Mit CRISPR-Cas kann dieses Gen ganz gezielt angesteuert und zerstört werden. Folglich lassen sich die Bakterien nicht mehr blau anfärben. Dazu gibt es mehrere Zusatzexperimente mit denen gezeigt wird, dass das Gen auf molekularer Ebene tatsächlich zerstört wurde.
Das Prinzip ist das gleiche, das bereits in der Humanmedizin für die Heilung schwerer Erbkrankheiten in klinischen Versuchen getestet wird und in der Tier- und Pflanzenzucht Anwendung findet
„Science Bridge wird mit dieser Zusammenarbeit keine Unmengen an Geld verdienen“ sagt Dr. Heike Ziegler, die als wissenschaftliche Koordinatorin die Projekte von Science Bridge betreut. „Das ist auch nicht unser Ziel. Als gemeinnütziger Verein sehen wir unsere Aufgabe in der Wissenschaftskommunikation und dazu gehört auch, wissenschaftliche Experimente im wahrsten Sinne des Wortes begreifbar zu machen“.
In Deutschland bietet Science Bridge die experimentellen Einblicke in die CRISPR-Cas Technologie unter professioneller Anleitung für Schulen und die Öffentlichkeit in den Sicherheitslaboren der Universität Kassel oder einem seiner Partnerlabore an. Beispielsweise haben im Oktober letzten Jahres Politiker des Deutschen Bundestages im Gläsernes Labor Berlin-Buch gemeinsam mit Science Bridge Mitarbeitern das CRISPR-Cas Experiment durchgeführt (Pressemitteilung vom 26.10.2020, sciencebridge.net/aktuelles/politik-an-der-genschere/.).
Science Bridge